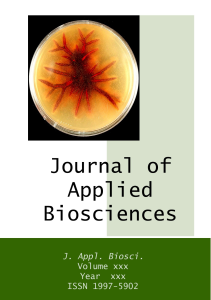

Journal of Applied Biosciences (J. Appl. Biosci.) [ISSN 1997 – 5902]
Volume 81: 7241 – 7252 Published September 30, 2014
Effet in vitro de différents niveaux NPK sur la croissance mycélienne et la sporulation de cinq pathogènes foliaires du riz : Helminthosporium sp. et Curvularia lunata
1Nawal IMRANI, Abdellatif OUAZZANI CHAHDI, Mohamed CHLIYEH, Jihane TOUATI, Amina OUAZZANI TOUHAMI, Rachid BENKIRANE et Allal DOUIRA
Université Ibn Tofaïl, Faculté des Sciences, Laboratoire de Botanique et de Protection des Plantes, B.P. 133, Kenitra, Maroc.
*Auteurs correspondants, E-mail : nawalimrani@yahoo.fr ; douiraallal@hotmail.com
Original submitted in on 21st August 2014. Published online at www.m.elewa.org on 30th September 2014. http://dx.doi.org/10.4314/jab.v81i1.10
RÉSUMÉ
Objectif : Le principal but de cette étude est d’examiner in vitro l’effet d’azote, de phosphore et de potassium, à différents niveaux, sur deux séquences biologiques de cinq pathogènes foliaires du riz (Oryza sativa) : Helminthosporium oryzae, H. sativum, H. australiensis, H. spiciferum et Curvularia lunata, notamment la croissance mycélienne et la sporulation.
Méthodologie et résultats : Trois milieux de culture organiques sont utilisés pour tester l’effet NPK sur la croissance mycélienne et la sporulation des cinq espèces fongiques testées : PDA, Farine de riz et Extrait de malt. Les sources d’azote, de phosphore et de potassium sont incorporées séparément dans le milieu de culture à des concentrations croissantes, 0,01 M (C1), 0,025 M (C2), 0,05 M (C3), 0,1 M (C4) et 0,15 M (C5), avant la stérilisation. Deux critères de notation sont pris en considération : la croissance mycélienne et la sporulation des espèces fongiques. Les résultats obtenus ont montré que les Helminthosporium et Curvularia lunata testés ont des comportements variables, croissance mycélienne et sporulation, sur des régimes nutritionnels en azote, phosphore et potassium. Ces comportements sont fonction de milieu de culture, la dose et la source de l’élément fertilisant incorporé.
Conclusion et application de résultats : Cette étude in vitro sur la croissance et la sporulation a montrée une grande adaptation des pathogènes foliaires du riz (Helminthosporium et C. lunata) aux différents niveaux de NPK testés, une telle adaptation laisse croire que l’apport des nutriments a plus d’effet sur l’hôte que sur le pathogène lui-même. Ces observations seront utiles pour aborder in vivo l’effet de la fertilisation sur les maladies foliaires du riz.
Effect of different levels of NPK on the mycelia growth and sporulation of five rice leaves pathogens: Helminthosporium sp. and Curvularia lunata
ABSTRACT.
Objective : The main purpose of this study is to investigate in vitro the effect of nitrogen, phosphorus and potassium, at various levels, of two biological sequences of five foliar pathogens of rice (Oryza sativa): Helminthosporium oryzae, H. sativum, H. australiensis, H. spiciferum et Curvularia lunata, including the mycelial growth and sporulation.
Methodology and Results: Three organic media cultures (PDA, rice meal and malt extract) were used to test the NPK effect on mycelia growth and sporulation of the five fungal species. The sources of nitrogen, phosphorus and potassium were incorporated separately in the culture medium at increasing concentrations, 0.01M (C1), 0.025 M (C2), 0.05M (C3), 0.1M (C4) and 0.15 M (C5), before the sterilization. Two scoring criteria were considered: mycelial growth and sporulation of the fungal species. The obtained results showed that the tested Curvularia lunata and Helminthosporium spp. have variable behaviors, mycelia growth and sporulation on nutritional diets on nitrogen, phosphorus and potassium. These behaviors depend on culture medium, the dose and source of fertilizing element incorporated.
Conclusion and results application. This in vitro study on the growth and sporulation has shown a great adaptation of rice foliar pathogens (Helminthosporium spp. and C. lunata) at different levels of the tested NPK. Such adaptation suggests that the nutrient intake has a greater effect on the host as in the pathogen itself. These observations will be useful to approach the in vivo effect of fertilization on rice foliar diseases.
FULL PAPER [Download Full Paper -PDF]
This is a comment to the webmaster. Your Imran Abstract JAB Vol.81 | ELEWA BIOSCIENCES website is missing out on at least 300 visitors per day. I have found a company which offers to dramatically increase your visitors to your site: http://xebyte.com/2py9 They offer 500 free visitors during their free trial period and I managed to get over 15,000 visitors per month using their services, you could also get lot more targeted visitors than you have now. Hope this helps 🙂 Take care.
This is a message to the admin. Your Imran Abstract JAB Vol.81 | ELEWA BIOSCIENCES website is missing out on at least 300 visitors per day. I have found a company which offers to dramatically increase your visitors to your site: http://bysb.eu/5rzn They offer 500 free visitors during their free trial period and I managed to get over 15,000 visitors per month using their services, you could also get lot more targeted traffic than you have now. Hope this helps 🙂 Take care.
You need targeted visitors for your Imran Abstract JAB Vol.81 | ELEWA BIOSCIENCES website so why not try some for free? There is a VERY POWERFUL and POPULAR company out there who now lets you try their traffic service for 7 days free of charge. I am so glad they opened their traffic system back up to the public! Check it out here: http://cutmes.esy.es/1z